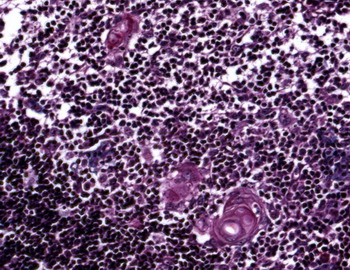

Microscopía de las óganos del sistema inmunitario
| INM-7
Timo (Tricrómico de Masson) |
Visión general: la sección histológica muestra en periferia una pequeña cápsula de tejido conjuntivo que delimita una organización en lobulillos. La estructura lobulillar tímica presenta la zona externa o cortical densamente celular más teñida que contrasta con la zona medular central clara. Los septos intertlobulillares aparecen repletos de vasos sanguineo llegando hasta la zona de unión corticomedular.
Visión específica: el análisis del lobulillo muestra una zona cortical formada mayoritariamente por linfocitos de pequeño tamaño con un disposición difusa y una zona medular que presenta menor contenido de linfocitos junto a células epiteliales configurando algunas de ellas típicos cuerpo de Hasall de heterogenidad morfológica marcada.
 |
 |
| INM-7
Timo (Tricrómico) 4x |
 |
INM-7
Timo (Tricrómico) 10x |
 |
|
 |
| INM-7
Timo (Tricrómico) 40x |
 |
INM-7
Timo (Tricrómico) 20x |
 |
 |
 |
| INM-7
Timo (Tricrómico) 20x |
 |
INM-7
Timo (HE) 20x |
 |
|
Vídeo
|
INM-8 Bazo (Hematoxilina-eosina) |
Visión general: la sección esplénica muestra una cápsula conectiva fibromuscular periférica que se continúa con tabiques o septos conteniendo estructuras vasculares. Se aprecian dos zonas diferenciales: la pulpa blanca situada periarteriolarmente y constituida por tejido linfoide difuso y nodular y la pulpa roja estructurada como espacios arquitecturales de senos venososo y cordones celulares de contenido fundamentalmente hematológico.
Visión específica: se analiza los componentes de la pulpa blanca configurando dos estructuras posibles: vaina linfoide periarteriolar (VLPA) únicamente constituida por tejido linfoide difuso y la VLPA con tejido linfoide difuso y un nódulo linfoide secundario excéntricamente ubicado. En la pulpa roja se distinguen con dificultad los espacios vasculares irregulares con luces escasamente aparentes repletos de sangre o senos venosos y los cordones de Billroth más sólidos de células macrofágicas en relación con células sanguíneas.
 |
 |
| INM-8
Bazo 4x |
 |
INM-8
Bazo 20x |
 |
Vídeo
| INM-9
Amígdala palatina (Hematoxilina-eosina) |
Visión general:se aprecia en superficie y en las criptas amigdalares el revestimiento epitelial pluriestratificado pavimentoso no queratinizado característico. A nivel subyacente destaca el tejido linfoide difuso y nodular con predominio de los folículos o nódulos secundarios.
Visión específica:el tejido linfoide difuso, que se encuentra en íntima relación con el epitelio y rodeando los nódulos linfoides, está constituido fundamentalmente por linfocitos de pequeño tamaño y plasmocitos. Los linfocitos están en intima relación con las células epiteliales de las criptas llegando a verse infiltradas por ellos en sus zonas más profundas. Los nódulos linfoides secundarios presentan una cubierta celular densa oscura constituida por los linfocitos de pequeño tamaño que configuran el manto o casquete y un centro claro con población celular heterogénea destacando celulas grandes centroblásticas junto con células de menor tamaño de núcleo hendido de tipo centrocítico de la estirpe linfocitaria.
 |
 |
| INM-9
Amígdala 4x |
 |
INM-9
Amígdala 20x |
 |
Vídeo
Vídeo
|